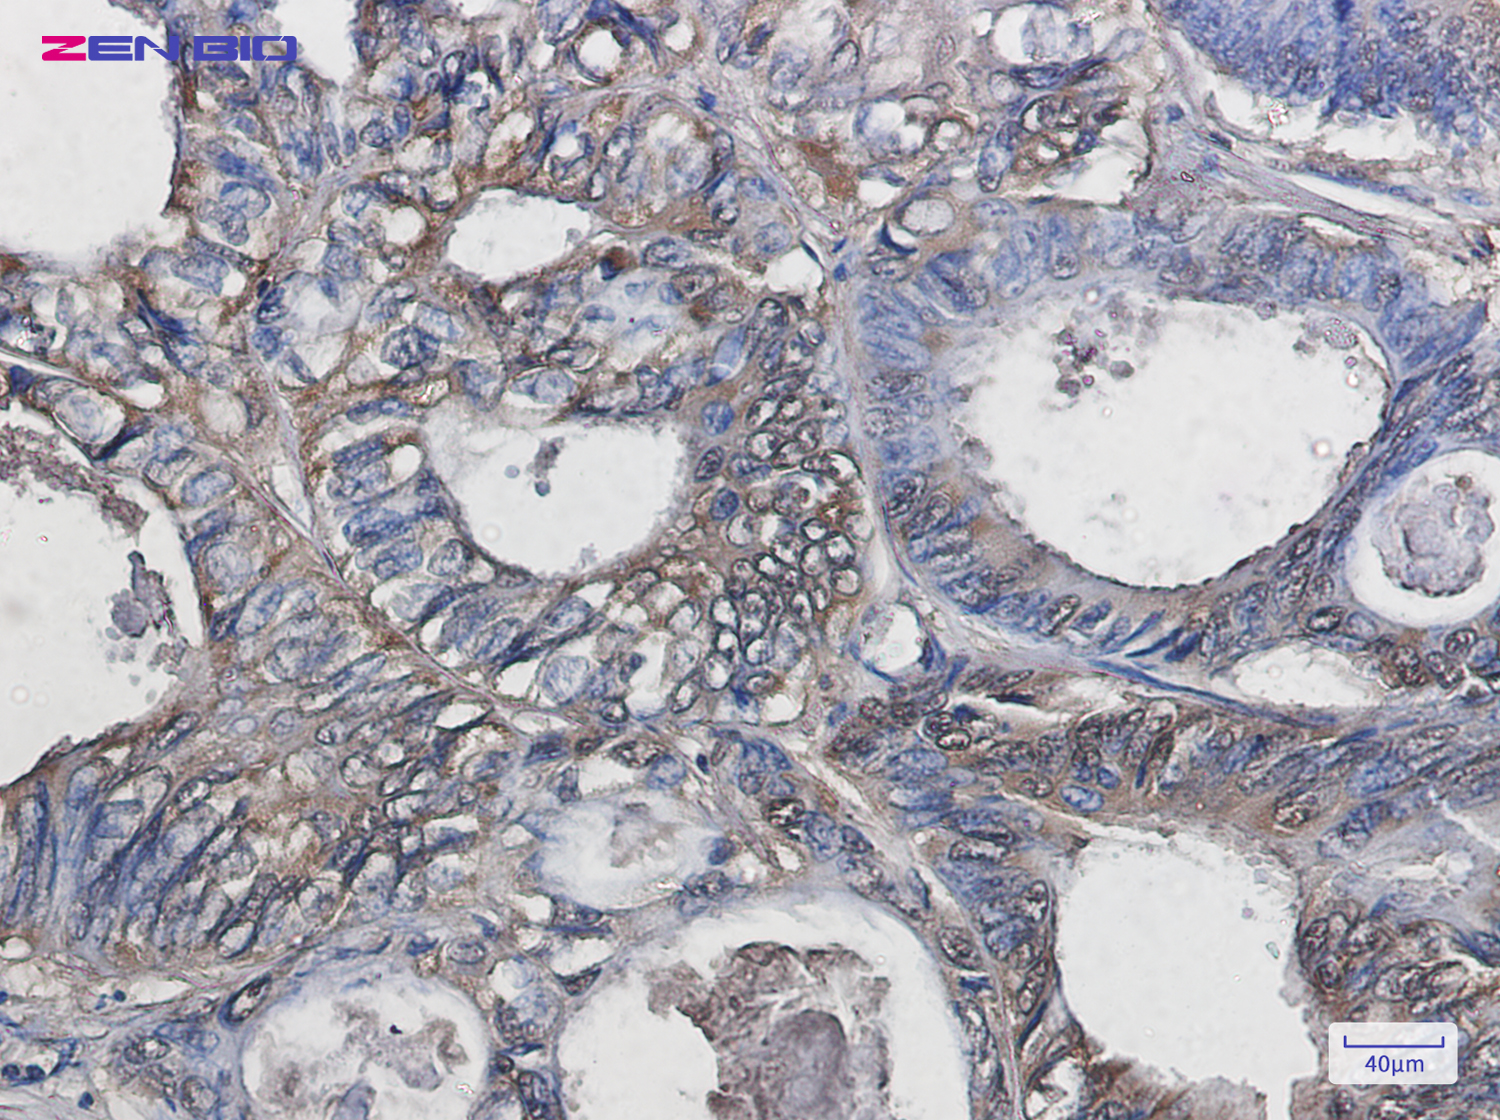
Immunohistochemistry of Superoxide Dismutase 1 in paraffin-embedded Human colon cancer tissue using Superoxide Dismutase 1 Rabbit pAb at dilution 1/20

-
Product Name
Anti-Superoxide Dismutase 1 Rabbit antibody
- Documents
-
Description
Superoxide Dismutase 1 Rabbit polyclonal antibody
-
Tested applications
WB, IHC-P, ICC/IF, FC
-
Species reactivity
Human, Rat
-
Alternative names
ALS; SOD; ALS1; IPOA; hSod1; HEL-S-44; homodimer antibody
-
Isotype
Rabbit IgG
-
Preparation
Antigen: A synthetic peptide of human Superoxide Dismutase 1
-
Clonality
Polyclonal
-
Formulation
Supplied in 50nM Tris-Glycine(pH 7.4), 0.15M Nacl, 40%Glycerol, 0.01% sodium azide and 0.05% BSA.
-
Storage instructions
Store at -20°C. Stable for 12 months from date of receipt.
-
Applications
WB: 1/5000
IHC: 1/20
ICC/IF: 1/20
FC: 1/20
-
Validations

Western blot detection of Superoxide Dismutase 1 in K562,Rat Brain,C6,3T3,Hela cell lysates using Superoxide Dismutase 1 Rabbit pAb(1:1000 diluted).Predicted band size:16kDa.Observed band size:18kDa.
Immunohistochemistry of Superoxide Dismutase 1 in paraffin-embedded Human colon cancer tissue using Superoxide Dismutase 1 Rabbit pAb at dilution 1/20
-
Background
Swiss-Prot Acc.P00441.Destroys radicals which are normally produced within the cells and which are toxic to biological systems.MiscellaneousThe protein (both wild-type and ALS1 variants) has a tendency to form fibrillar aggregates in the absence of the intramolecular disulfide bond or of bound zinc ions. These aggregates may have cytotoxic effects. Zinc binding promotes dimerization and stabilizes the native form.
Related Products / Services
Please note: All products are "FOR RESEARCH USE ONLY AND ARE NOT INTENDED FOR DIAGNOSTIC OR THERAPEUTIC USE"
